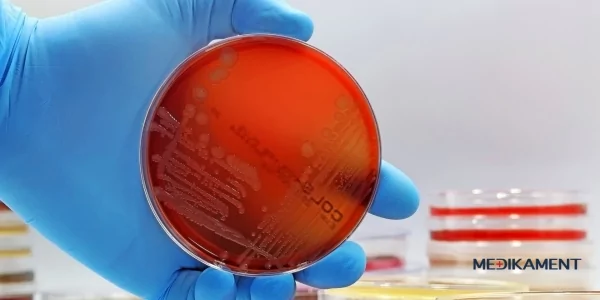

Salmonelóza je infekčné ochorenie spôsobené baktériami rodu salmonela, ktoré sú jednou z najčastejších príčin potravinových otrav. Postihuje tráviaci systém a môže vyvolať silné príznaky, ktoré pacientov vyraďujú z bežného života na niekoľko dní až týždňov. Salmonelóza sa často spája so zle spracovanými alebo kontaminovanými potravinami a jej liečba môže byť náročná, ak nie je diagnostikovaná včas. Prejavy ochorenia sa môžu líšiť podľa veku a zdravotného stavu pacienta, pričom deti a starší ľudia sú na túto infekciu náchylnejší. V tomto článku sa pozrieme na to, čo salmonelózu spôsobuje, aké sú jej príznaky, liečba a ako sa jej dá predísť.

Čo je to salmonelóza?
Salmonelóza je akútne infekčné ochorenie, ktoré je spôsobené baktériami z rodu salmonela. Tento typ infekcie patrí medzi najčastejšie gastrointestinálne ochorenia na svete. Hlavným cieľom baktérií je napadnúť črevá človeka, kde spôsobujú zápal a podráždenie, čo vedie k nepríjemným príznakom ako sú hnačka, bolesti brucha a horúčka. Ochorenie postihuje milióny ľudí ročne a hoci väčšina prípadov prebieha v ľahkej forme, môže byť v závažných prípadoch život ohrozujúca, najmä pre starších ľudí, deti a ľudí so zníženou imunitou. Práve preto je dôležité vedieť, ako sa salmonelóze vyhnúť a ako s ňou bojovať, ak už sa ňou nakazíte.
Čo salmonelózu spôsobuje?
Pôvodcom salmonelózy sú baktérie rodu salmonela, ktoré sa vyskytujú v kontaminovaných potravinách a vode. Hlavným zdrojom nákazy sú zvieratá, najmä hydina, hovädzie mäso, vajcia a mliečne výrobky, ktoré neprešli dostatočnou tepelnou úpravou. Často dochádza k nákaze pri konzumácii nedovareného mäsa alebo konzumácii potravín pripravených v nehygienických podmienkach. Prenos salmonely sa uskutočňuje najmä cez jedlo, no baktérie môžu byť prítomné aj v špinavej vode alebo sa môžu šíriť kontaktom s infikovanými osobami. Z tohto dôvodu je mimoriadne dôležité dodržiavať zásady hygieny pri manipulácii s potravinami a venovať pozornosť správnej tepelnej úprave.
Kde všade sa môže salmonela nachádzať?
Salmonela sa môže vyskytovať v rôznych potravinách, pričom najčastejším zdrojom infekcie sú vajcia, hydina a mliečne výrobky. Salmonela z vajec je bežným spôsobom nákazy, keďže baktérie môžu byť prítomné na škrupinách alebo vo vnútri vajíčka. Nákaza sa môže šíriť aj prostredníctvom kontaminovaného mäsa, ktoré nebolo dostatočne tepelne upravené, a tiež cez výrobky, ktoré prichádzajú do styku s kontaminovanou vodou. Salmonela sa však môže šíriť aj cez čerstvú zeleninu, ovocie a iné potraviny, ak prídu do kontaktu s baktériou napríklad počas prípravy jedla v nehygienických podmienkach. Salmonela je vysoko odolná baktéria, ktorá prežíva aj v mrazenej forme, a preto je dôležité byť opatrný pri všetkých druhoch potravín.
Ihneď k odoslaniu
Aké druhy salmonel rozlišujeme?
Existuje mnoho rôznych druhov baktérií rodu salmonela, no najčastejšie sa stretávame s dvoma hlavnými typmi: Salmonella enteritidis a Salmonella typhi. Zatiaľ čo Salmonella enteritidis spôsobuje najmä gastrointestinálne infekcie a potravinové otravy, Salmonella typhi je pôvodcom ochorenia nazývaného týfus, ktoré je závažnejšie a vyžaduje si intenzívnejšiu liečbu. Oba druhy salmonely sa prenášajú cez kontaminované potraviny, no priebeh ochorení sa môže líšiť. Kým salmonelóza spôsobená Salmonella enteritidis sa prejavuje hlavne tráviacimi problémami, týfus môže postihnúť aj ďalšie systémy v tele, ako je obehový a nervový systém, a môže byť život ohrozujúci.
Aké sú príznaky salmonelózy?
Príznaky salmonelózy sa zvyčajne prejavujú do 6 až 72 hodín po nákaze. Medzi najčastejšie príznaky patrí hnačka, nevoľnosť, zvracanie, bolesti brucha, horúčka a únava. Salmonela a jej príznaky môžu zahŕňať aj bolesť hlavy, svalovú slabosť a dehydratáciu, najmä ak je hnačka intenzívna. U detí a starších ľudí môže infekcia spôsobiť vážnejšie prejavy, ako sú ťažkosti s dýchaním alebo nepravidelný tep srdca. Salmonela stolica môže obsahovať krv alebo hlien, čo je známka závažnejšej infekcie. Príznaky môžu trvať od niekoľkých dní až po dva týždne, v závislosti od závažnosti ochorenia a celkového zdravotného stavu pacienta.
Aká je inkubačná doba salmonelózy?
Salmonelóza má relatívne krátku inkubačnú dobu, ktorá sa pohybuje medzi 6 a 72 hodinami po kontakte s baktériou. V tomto čase sa baktérie množia v tráviacom systéme, čo vedie k postupnému rozvoju príznakov. Počas inkubačnej doby je pacient často už infekčný a môže prenášať ochorenie na iných ľudí, najmä v prípadoch, keď nie sú dodržiavané hygienické zásady. Prenos salmonely počas inkubačnej doby môže nastať aj prostredníctvom priamych kontaktov alebo zdieľania predmetov osobnej hygieny. Preto je dôležité, aby každý, kto sa cíti byť ohrozený alebo vystavený riziku nákazy, dodržiaval zvýšené hygienické opatrenia, aby sa predišlo ďalšiemu šíreniu infekcie.
Ako sa salmonelóza lieči?
Salmonela a liečba je zameraná hlavne na zmiernenie príznakov a udržiavanie hydratácie organizmu. Odporúča sa pitie rehydratačných roztokov, ktoré pomáhajú nahradiť tekutiny a elektrolyty, ktoré telo počas ochorenia intenzívne stráca. Rehydratačné roztoky obsahujú správne množstvo vody, soli a cukru, čo umožňuje telu tieto látky rýchlejšie vstrebávať a obnoviť rovnováhu tekutín a elektrolytov.
V prípade miernych infekcií nie je liečba antibiotikami zvyčajne potrebná, pretože organizmus sa s baktériami vysporiada sám. Diéta počas liečby zahŕňa konzumáciu ľahko stráviteľných jedál, ako sú ryža, banány, varené zemiaky a iné nízko dráždivé potraviny. Veľmi dôležité je prijímať dostatok tekutín, najmä ak pacient trpí silnou hnačkou. V závažných prípadoch, keď sa stav pacienta zhoršuje, môže byť potrebná hospitalizácia a podávanie antibiotík (ampicilín, streptomycín, trimetoprim/sulfametoxazol) a intravenóznej hydratácie v nemocničnom prostredí. Počas liečby sa odporúča užívať probiotiká, ktoré prispievajú k obnove črevnej mikroflóry a zmierneniu príznakov, medzi ktoré patrí najmä hnačka. Veľmi obľúbené je probiotikum Hylak forte, ktoré sa javí ako účinné aj počas liečby salmonelózy.
Ako dlho trvá liečba salmonely závisí od závažnosti ochorenia, no v priemere sa symptómy zmierňujú do 7 až 10 dní. U niektorých ľudí však môže trvať dlhšie, kým sa úplne zotavia, najmä ak sú komplikácie alebo ďalšie zdravotné problémy.
Aké komplikácie môže salmonelóza spôsobiť?
Hoci väčšina ľudí prekoná salmonelózu bez vážnych následkov, v niektorých prípadoch môže ochorenie viesť k závažným komplikáciám. Medzi najčastejšie patrí dehydratácia spôsobená silnou hnačkou a zvracaním, ktorá môže byť obzvlášť nebezpečná pre deti, starších ľudí a osoby so zníženou imunitou. Salmonelóza u detí môže spôsobiť vážnu dehydratáciu, ktorá vyžaduje hospitalizáciu a podávanie intravenóznych tekutín. Ďalšou komplikáciou môže byť infekcia krvi (bakteriémia), keď baktérie preniknú z čriev do krvného obehu a spôsobia systémové infekcie. Táto situácia si vyžaduje okamžitú lekársku starostlivosť a podávanie antibiotík. V extrémnych prípadoch môže infekcia viesť k zápalu kĺbov, zápalu mozgových blán alebo obličiek. Dlhodobé následky môžu zahŕňať chronické problémy s tráviacim systémom alebo artritídu, ktorá sa môže objaviť u ľudí, ktorí prekonali ťažkú formu salmonelózy. Preto je dôležité venovať zvýšenú pozornosť liečbe a sledovať stav pacienta aj po odznení akútnych príznakov.
Aká je prevencia salmonelózy?
Hoci väčšina ľudí prekoná salmonelózu bez vážnych následkov, v niektorých prípadoch môže ochorenie viesť k závažným komplikáciám. Medzi najčastejšie patrí dehydratácia spôsobená silnou hnačkou a zvracaním, ktorá môže byť obzvlášť nebezpečná pre deti, starších ľudí a osoby so zníženou imunitou. Salmonelóza u detí môže spôsobiť vážnu dehydratáciu, ktorá vyžaduje hospitalizáciu a podávanie intravenóznych tekutín. Ďalšou komplikáciou môže byť infekcia krvi (bakteriémia), keď baktérie preniknú z čriev do krvného obehu a spôsobia systémové infekcie. Táto situácia si vyžaduje okamžitú lekársku starostlivosť a podávanie antibiotík. V extrémnych prípadoch môže infekcia viesť k zápalu kĺbov, zápalu mozgových blán alebo obličiek. Dlhodobé následky môžu zahŕňať chronické problémy s tráviacim systémom alebo artritídu, ktorá sa môže objaviť u ľudí, ktorí prekonali ťažkú formu salmonelózy. Preto je dôležité venovať zvýšenú pozornosť liečbe a sledovať stav pacienta aj po odznení akútnych príznakov.

Aká je prevencia salmonelózy?
Prevencia salmonelózy spočíva predovšetkým v dodržiavaní hygienických zásad pri príprave a skladovaní potravín. Salmonela prenos sa najčastejšie deje prostredníctvom kontaminovaných potravín, preto je dôležité dôkladne umývať ruky, riad a povrchy v kuchyni, najmä po manipulácii so surovým mäsom a vajcami. Salmonela z vajec môže byť nebezpečná, preto vajcia pred použitím dôkladne umyte a varte alebo pečte na dostatočne vysokých teplotách, aby sa zničili všetky baktérie. Hydina, mäso a mliečne výrobky by mali byť skladované pri správnych teplotách a nikdy by nemali byť konzumované surové alebo nedovarené. Vyhnite sa konzumácii potravín z neoverených zdrojov, ktoré by mohli byť pripravené v nehygienických podmienkach.
Ďalším dôležitým krokom v prevencii je oddelenie surových a pripravených potravín, aby nedošlo ku kontaminácii. Zeleninu a ovocie umývajte dôkladne, najmä ak ich plánujete konzumovať surové. Dbajte aj na správne skladovanie jedla, aby ste predišli šíreniu baktérií. Salmonelózna karanténa je v prípade nákazy dôležitá, najmä ak sa u pacienta prejavia silné príznaky a môže šíriť ochorenie ďalej. Ak sa objaví podozrenie na salmonelózu, pacient by mal zostať doma a vyhýbať sa kontaktu s ostatnými, kým príznaky úplne neustúpia.
Salmonelóza je závažné infekčné ochorenie, ktoré môže postihnúť každého, kto nedodržiava základné hygienické opatrenia pri príprave a konzumácii potravín. Salmonela sa ľahko šíri, najmä cez kontaminované potraviny ako surové mäso, vajcia a mliečne výrobky. Ochorenie môže byť veľmi nepríjemné a v niektorých prípadoch viesť k vážnym komplikáciám, najmä u zraniteľných skupín, ako sú deti a starší ľudia. Salmonelóza príznaky zahŕňajú silnú hnačku, bolesti brucha, horúčku a dehydratáciu, ktoré môžu trvať niekoľko dní až týždňov. Ako dlho trvá liečba salmonely závisí od závažnosti infekcie, no v priemere sa príznaky zmierňujú do 7 až 10 dní.
Prevencia je kľúčová a zahŕňa dodržiavanie správnej hygieny, správnu tepelnú úpravu potravín a opatrnosť pri manipulácii s rizikovými potravinami. Salmonela prenos môže byť obmedzený, ak sa budete držať týchto jednoduchých zásad. Dodržiavaním preventívnych opatrení sa môžete vyhnúť nepríjemnostiam spojeným s touto infekciou a ochrániť svoje zdravie.
Zdroje
DVOŘÁK M., 2021. Salmonelóza (salmonela)-příznaky, přenos a léčba. Dostupné na : https://euc.cz/clanky-a-novinky/clanky/salmoneloza-salmonela-priznaky-prenos-a-lecba/
GAL-MOR, O. et al. 2014. Salmonella Same species, different diseases: How and why typhoidal and non-typhoidal Salmonella enterica serovars differ. In Frontiers in microbiology [online], vol. 5, p. 391. ISSN 1664-302X. doi.org/10.3389/fmicb.2014.00391
CHENG-HSUN, Ch. – LIN-HUI, S. 2017. Salmonella, non-typhoidal species (S. Choleraesuis, S. Enteritidis, S. Hadar, S. Typhimurium) [online]. Dostupné na: http://www.antimicrobe.org/b258.asp
LIPTÁKOVÁ A. a kol. 2019. Lekárska mikrobiologia. Herba, spol. s r.o., Bratislava. 2019. ISBN 978-80-89631-91-9
WHO. 2018. Salmonella (non-typhoidal) [online], aktualizované 2020. Dostupné na: https://www.who.int/en/news-room/fact-sheets/detail/salmonella-(nontyphoidal)